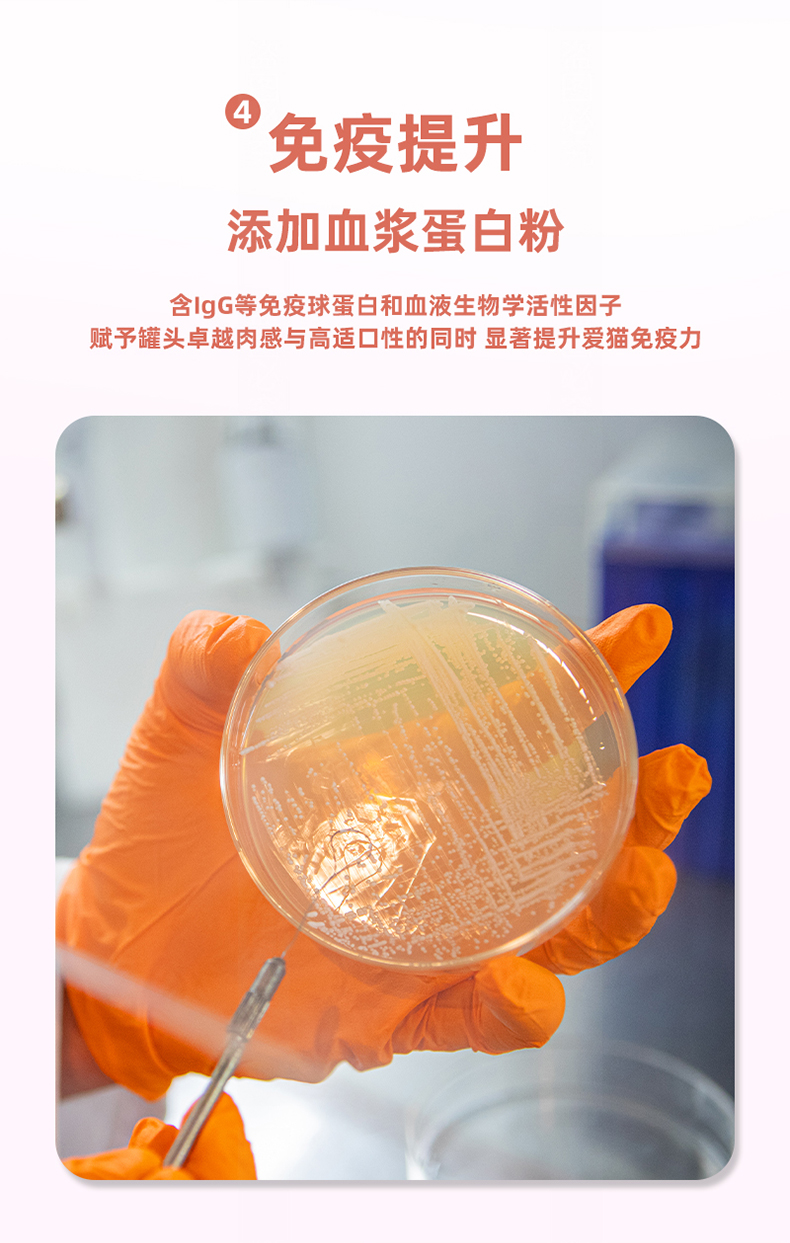

联系我们
联系电话:18123689623
邮箱:
客户服务:customerservice@trivetpet.com
寻求合作:sales@trivetpet.com
联系地址:广东省深圳市宝安区石岩街道洲石路与料坑大道交叉口恒胜亿物流园A7栋4楼
联系我们
联系电话:18123689623
邮箱:
客户服务:customerservice@trivetpet.com
寻求合作:sales@trivetpet.com
联系地址:广东省深圳市宝安区石岩街道洲石路与料坑大道交叉口恒胜亿物流园A7栋4楼